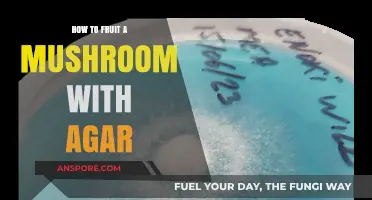
Master Mushroom Fruiting: Agar Techniques for Bountiful Harvests

Fruiting blue oyster mushrooms is a rewarding process that allows you to cultivate these vibrant, edible fungi at home. Blue oyster mushrooms (*Pleurotus ostreatus var. columbinus*) are known for their striking blue-gray caps and rich, savory flavor, making them a popular choice for both culinary enthusiasts and home growers. To successfully fruit these mushrooms, you’ll need to create optimal conditions that mimic their natural environment, including proper substrate preparation, humidity control, and temperature management. The process begins with inoculating a suitable substrate, such as straw or sawdust, with blue oyster mushroom spawn, followed by a period of colonization. Once fully colonized, the substrate is exposed to fruiting conditions, which typically involve increased humidity, cooler temperatures, and indirect light. With patience and attention to detail, you can enjoy a bountiful harvest of blue oyster mushrooms, ready to enhance your meals with their unique texture and taste.
| Characteristics | Values |
|---|---|
| Substrate | Straw, sawdust, coffee grounds, or a combination. Sterilized or pasteurized. |
| Spawn Type | Grain spawn (wheat, rye, millet) or sawdust spawn. |
| Spawn Ratio | 10-20% spawn to substrate by weight. |
| Moisture Content | 60-70% moisture in substrate. |
| Incubation Temperature | 70-75°F (21-24°C) for mycelium colonization (2-4 weeks). |
| Fruiting Temperature | 55-70°F (13-21°C). |
| Humidity | 85-95% during fruiting. |
| Light | Indirect natural light or 12 hours of fluorescent light daily. |
| Fresh Air Exchange | Good ventilation is crucial; 2-3 air exchanges per hour. |
| Pinning Technique | Cold shock (40°F/4°C for 24 hours) or light misting to induce pin formation. |
| Harvest Time | Harvest when caps are still curled inward and gills are exposed but not dropping spores. |
| Yield | 0.5-1 pound per 5 pounds of substrate, depending on conditions. |
| Common Issues | Contamination (mold, bacteria), low humidity causing aborts, or improper temperature leading to slow growth. |
| Special Notes | Blue oysters are more temperature-sensitive than other oyster varieties; avoid extreme fluctuations. |
Explore related products
$29.99
What You'll Learn
- Spawn Selection: Choose high-quality blue oyster mushroom spawn for optimal fruiting success
- Substrate Preparation: Use straw, sawdust, or coffee grounds properly pasteurized for mushroom growth
- Humidity Control: Maintain 80-90% humidity for healthy pin formation and fruiting
- Light Requirements: Provide indirect natural light or low-intensity artificial light for fruiting
- Harvesting Tips: Pick mushrooms when caps flatten or curl up for best flavor

Spawn Selection: Choose high-quality blue oyster mushroom spawn for optimal fruiting success
When embarking on the journey to fruit blue oyster mushrooms, the first and most critical step is spawn selection. The spawn serves as the foundation for your mushroom cultivation, and its quality directly influences the success of fruiting. High-quality blue oyster mushroom spawn ensures vigorous mycelial growth, robust fruiting bodies, and higher yields. To begin, source your spawn from reputable suppliers known for their expertise in mushroom cultivation. Look for suppliers who provide detailed information about their spawn, including the strain’s origin, viability, and storage conditions. Avoid cheap or unverified sources, as low-quality spawn may contain contaminants or weak mycelium, leading to poor fruiting or crop failure.
Next, consider the type of spawn you need. Blue oyster mushroom spawn is typically available in two forms: grain spawn and plug spawn. Grain spawn, such as rye or wheat berries colonized by mycelium, is ideal for indoor cultivation in bags or trays. It is fast-colonizing and provides a dense network of mycelium, promoting quick fruiting. Plug spawn, on the other hand, consists of wooden dowels inoculated with mycelium and is best suited for outdoor log or stump cultivation. Choose the spawn type that aligns with your growing environment and goals. For most beginners, grain spawn is recommended due to its versatility and ease of use.
Inspect the spawn carefully before use. High-quality spawn should appear healthy, with fully colonized substrate and no signs of mold, discoloration, or off-odors. The mycelium should be white and vibrant, indicating active growth. If you’re purchasing spawn online, ensure it is shipped in a timely manner and stored properly upon arrival. Spawn should be kept in a cool, dark place until you’re ready to use it, as exposure to heat or light can degrade its viability. Always follow the supplier’s instructions for handling and storing the spawn to maintain its quality.
Another crucial factor in spawn selection is choosing the right strain of blue oyster mushrooms. Different strains may vary in growth rate, fruiting potential, and resistance to environmental conditions. Research strains that are well-suited to your climate and growing setup. For example, some strains perform better in cooler temperatures, while others are more tolerant of humidity fluctuations. If possible, select a strain known for its prolific fruiting and adaptability to indoor conditions. Reputable suppliers often provide strain-specific information to help you make an informed decision.
Lastly, consider the quantity of spawn needed for your project. Blue oyster mushrooms require a sufficient amount of spawn to colonize the substrate effectively and initiate fruiting. As a general rule, use a spawn-to-substrate ratio of 5-10%, depending on the growing method. For example, if you’re using a 5-pound bag of straw or sawdust, you’ll need 4 to 8 ounces of grain spawn. Under-inoculating the substrate can lead to slow colonization and increased risk of contamination, while over-inoculating may waste resources without significant benefits. Calculating the correct amount of spawn ensures optimal mycelial growth and maximizes your chances of successful fruiting.
In summary, selecting high-quality blue oyster mushroom spawn is a cornerstone of successful fruiting. Prioritize reputable suppliers, choose the appropriate spawn type and strain, inspect the spawn for quality, and use the correct quantity for your substrate. By investing time and effort into spawn selection, you lay a strong foundation for healthy mycelial growth and abundant mushroom harvests.
Chaga Mushroom Benefits: Superfood Explained
You may want to see also

Substrate Preparation: Use straw, sawdust, or coffee grounds properly pasteurized for mushroom growth
Substrate preparation is a critical step in fruiting blue oyster mushrooms, as it provides the necessary nutrients and environment for mycelium growth and subsequent mushroom development. When using straw, sawdust, or coffee grounds, proper pasteurization is essential to eliminate competing organisms and create a sterile medium for the mushroom mycelium to thrive. Begin by selecting your substrate material—wheat straw is commonly used due to its availability and ease of pasteurization, while sawdust and coffee grounds offer alternative options with varying nutrient profiles. Ensure the material is clean and free from mold or contaminants before proceeding.
To pasteurize straw, fill a large container or barrel with water and heat it to approximately 160-180°F (71-82°C). Submerge the straw in the hot water for 1-2 hours, stirring occasionally to ensure even heat distribution. This process kills unwanted bacteria and fungi while preserving enough nutrients for the mushroom mycelium. After pasteurization, drain the straw thoroughly and allow it to cool to room temperature. Excess moisture can lead to anaerobic conditions, so it’s crucial to squeeze out as much water as possible. For sawdust or coffee grounds, a similar pasteurization process can be applied, but these materials may require additional supplementation with bran or nutrients to support robust mycelium growth.
Once pasteurized, the substrate must be properly hydrated and prepared for inoculation. Aim for a moisture content of around 60-70%, which can be achieved by adjusting the water content during pasteurization or by misting the substrate lightly after cooling. Too much moisture can cause waterlogging, while too little can hinder mycelium colonization. Mix the pasteurized substrate with the blue oyster mushroom spawn at a ratio typically recommended by the spawn provider, often around 5-10% spawn to substrate by weight. Ensure the spawn is evenly distributed throughout the material to promote uniform colonization.
After inoculation, the substrate should be placed in a suitable container, such as a plastic bag with filter patches or a perforated container, to allow for gas exchange while maintaining humidity. Keep the substrate in a dark, warm environment with temperatures between 68-75°F (20-24°C) to encourage mycelium growth. Over the next few weeks, the mycelium will colonize the substrate, breaking down the material and preparing it for fruiting. Regularly monitor for contamination and ensure proper ventilation to prevent mold or bacterial growth.
Once fully colonized, the substrate is ready for fruiting conditions. Introduce light, reduce temperature slightly to around 60-65°F (15-18°C), and increase humidity to 85-95% to trigger mushroom formation. Proper substrate preparation and pasteurization are foundational to successful blue oyster mushroom cultivation, ensuring a healthy and productive harvest. By mastering this step, growers can create an optimal environment for these vibrant mushrooms to thrive.
Reishi Mushroom Benefits: How It Supports Liver Health and Detoxification
You may want to see also

Humidity Control: Maintain 80-90% humidity for healthy pin formation and fruiting
Maintaining optimal humidity levels is critical for successfully fruiting blue oyster mushrooms. The ideal humidity range for healthy pin formation and fruiting is between 80% and 90%. At this level, the mushrooms receive the moisture they need to develop without becoming waterlogged or susceptible to mold and other contaminants. To achieve this, you’ll need to monitor and adjust the environment consistently, as fluctuations outside this range can hinder growth or cause the mushrooms to dry out and abort fruiting.
One effective method to control humidity is by using a humidifier in your growing area. Choose a humidifier with adjustable settings and a hygrometer to accurately measure the humidity levels. Place the humidifier near the mushroom substrate but ensure it doesn't spray directly onto the mushrooms, as this can lead to waterlogging. Regularly check the hygrometer to ensure the humidity stays within the 80-90% range, adjusting the humidifier as needed. If your growing environment is naturally humid, you may only need to mist the air lightly with a spray bottle to maintain the desired levels.
Another technique to manage humidity is by using a humidity tent or chamber. This can be as simple as a clear plastic container or a DIY setup with a plastic sheet draped over a frame. The tent traps moisture around the mushrooms, creating a microclimate that retains humidity. Ensure the tent is well-ventilated to prevent carbon dioxide buildup, which can stunt growth. Open the tent periodically to allow fresh air exchange while monitoring humidity levels to avoid dropping below 80%.
For those growing blue oyster mushrooms in a monotub or similar setup, covering the substrate with a damp cloth or using a layer of perlite can help maintain humidity. The perlite acts as a reservoir, slowly releasing moisture into the air as it dries. Mist the perlite lightly every few days to keep it damp, but not soggy. This method, combined with occasional misting of the mushroom environment, can help stabilize humidity levels without over-saturating the substrate.
Lastly, environmental factors like temperature and air circulation play a role in humidity control. Higher temperatures can cause moisture to evaporate more quickly, so ensure your growing area remains within the optimal temperature range for blue oyster mushrooms (60-75°F or 15-24°C). Proper air circulation is also essential to prevent stagnant air, which can lead to mold. Use a small fan on a low setting to maintain airflow without drying out the environment. By carefully managing these factors alongside humidity, you’ll create the ideal conditions for healthy pin formation and abundant fruiting of blue oyster mushrooms.
Evolution of Tiny Mushrooms: From Spores to Caps
You may want to see also
Explore related products

Light Requirements: Provide indirect natural light or low-intensity artificial light for fruiting
Blue oyster mushrooms (*Pleurotus ostreatus*) are not only a culinary delight but also a fascinating species to cultivate at home. When it comes to fruiting these mushrooms, light requirements play a crucial role in triggering and supporting the development of their distinctive caps and gills. While blue oysters are primarily saprotrophic and do not rely on light for energy like plants do, they still require specific light conditions to initiate and sustain fruiting. The key is to provide indirect natural light or low-intensity artificial light, as this mimics their natural habitat and signals to the mycelium that it’s time to produce fruit bodies.
Indirect natural light is ideal for fruiting blue oyster mushrooms. Place your growing container near a window with filtered sunlight, such as one covered by a sheer curtain or facing north. Direct sunlight can be too intense and may dry out the substrate or overheat the mushrooms, hindering growth. The goal is to create a gentle, consistent light exposure that encourages the mycelium to form primordia—the tiny pins that develop into mature mushrooms. If natural light is limited, especially during winter months or in windowless spaces, low-intensity artificial light can be used as a substitute.
When using artificial light, opt for cool-white fluorescent bulbs or LED grow lights with a low luminescence. Position the light source 12–18 inches above the mushroom container, ensuring it’s not too close to avoid overheating. A light cycle of 10–12 hours per day is sufficient to stimulate fruiting without overwhelming the mycelium. Avoid using warm or high-intensity lights, as they can stress the mushrooms and disrupt the fruiting process. Consistency is key—maintain a regular light schedule to provide the mycelium with a stable environment.
It’s important to note that while light is necessary for fruiting, blue oyster mushrooms do not require darkness for pinning or growth. Unlike some mushroom species, they can tolerate continuous low light without adverse effects. However, excessive darkness may delay fruiting, as light acts as a critical environmental cue. Monitor the humidity and temperature alongside light conditions, as these factors work together to create an optimal fruiting environment.
In summary, providing indirect natural light or low-intensity artificial light is essential for fruiting blue oyster mushrooms. This light exposure triggers the mycelium to develop fruit bodies while ensuring the mushrooms remain healthy and productive. By maintaining the right balance of light intensity and duration, you can successfully cultivate a bountiful harvest of these beautiful and delicious mushrooms.
Perfectly Preserving Black Chanterelles: A Guide to Drying Mushrooms
You may want to see also

Harvesting Tips: Pick mushrooms when caps flatten or curl up for best flavor
Harvesting blue oyster mushrooms at the right time is crucial for maximizing flavor, texture, and yield. The key indicator that your mushrooms are ready for harvest is the state of their caps. When the caps begin to flatten or curl upward, it signals that the mushrooms have reached peak maturity. Harvesting at this stage ensures the best flavor profile, as the mushrooms are neither too young nor overly mature. Younger mushrooms with tightly closed caps may lack the full depth of flavor, while those with fully opened or downward-facing caps can become tough and less palatable. Monitoring the caps daily is essential, as blue oyster mushrooms can progress quickly from prime harvest condition to overripe.
To harvest, gently grasp the mushroom at its base and twist it clockwise or counterclockwise while pulling slightly. This method ensures the mushroom releases cleanly from the substrate without damaging the mycelium or nearby pins. Avoid cutting the mushrooms with a knife, as this can introduce contaminants and harm future flushes. If the mushroom does not come off easily, it may not be fully ready, so check back the following day. Proper harvesting technique also helps maintain the health of the growing substrate, allowing for multiple flushes of mushrooms over time.
Timing is critical when harvesting blue oyster mushrooms, as they can deteriorate rapidly once past their prime. Caps that have flattened or begun to curl up are in the ideal window for picking. At this stage, the mushrooms have developed their signature earthy, slightly nutty flavor and tender texture. Waiting too long can result in caps that uncurl completely or develop a slimy texture, indicating the mushrooms are overripe. Regularly inspecting your growing environment and harvesting promptly when the caps reach this stage will yield the best results.
Environmental factors can influence the speed at which blue oyster mushrooms mature, so it’s important to stay observant. Humidity, temperature, and airflow all play a role in how quickly the caps flatten or curl. In optimal conditions, mushrooms may be ready for harvest within 5 to 7 days after the primordia (tiny mushroom pins) first appear. If you notice the caps starting to flatten or curl, it’s a clear sign to begin harvesting. Ignoring this window can lead to missed opportunities for peak flavor and texture.
Finally, harvesting blue oyster mushrooms when the caps flatten or curl up not only ensures the best culinary experience but also encourages the substrate to produce additional flushes. After harvesting, the mycelium can redirect its energy into forming new pins, extending the productive life of your grow. By focusing on this specific stage of maturity, you’ll consistently enjoy high-quality mushrooms while supporting the health and longevity of your cultivation efforts. Always harvest with care and attention to detail for the best possible results.
Fruit Bats vs. Mushrooms: Which Contributes More to Ecosystems?
You may want to see also
Frequently asked questions
Blue oyster mushrooms fruit best at temperatures between 55°F and 75°F (13°C and 24°C). Avoid extreme heat or cold, as it can hinder fruiting.
Maintain humidity levels between 80-95% for optimal fruiting. Use a humidifier or mist the mushrooms regularly to keep the environment moist.
Shock the mycelium by exposing it to fresh air, cooler temperatures, and indirect light. This mimics the transition from colonization to fruiting conditions.
Mist the mushrooms 2-3 times daily to maintain high humidity. Avoid overwatering, as excessive moisture can lead to contamination or mold.
Fruiting typically begins within 7-14 days after initiating the process, depending on environmental conditions and the health of the mycelium.